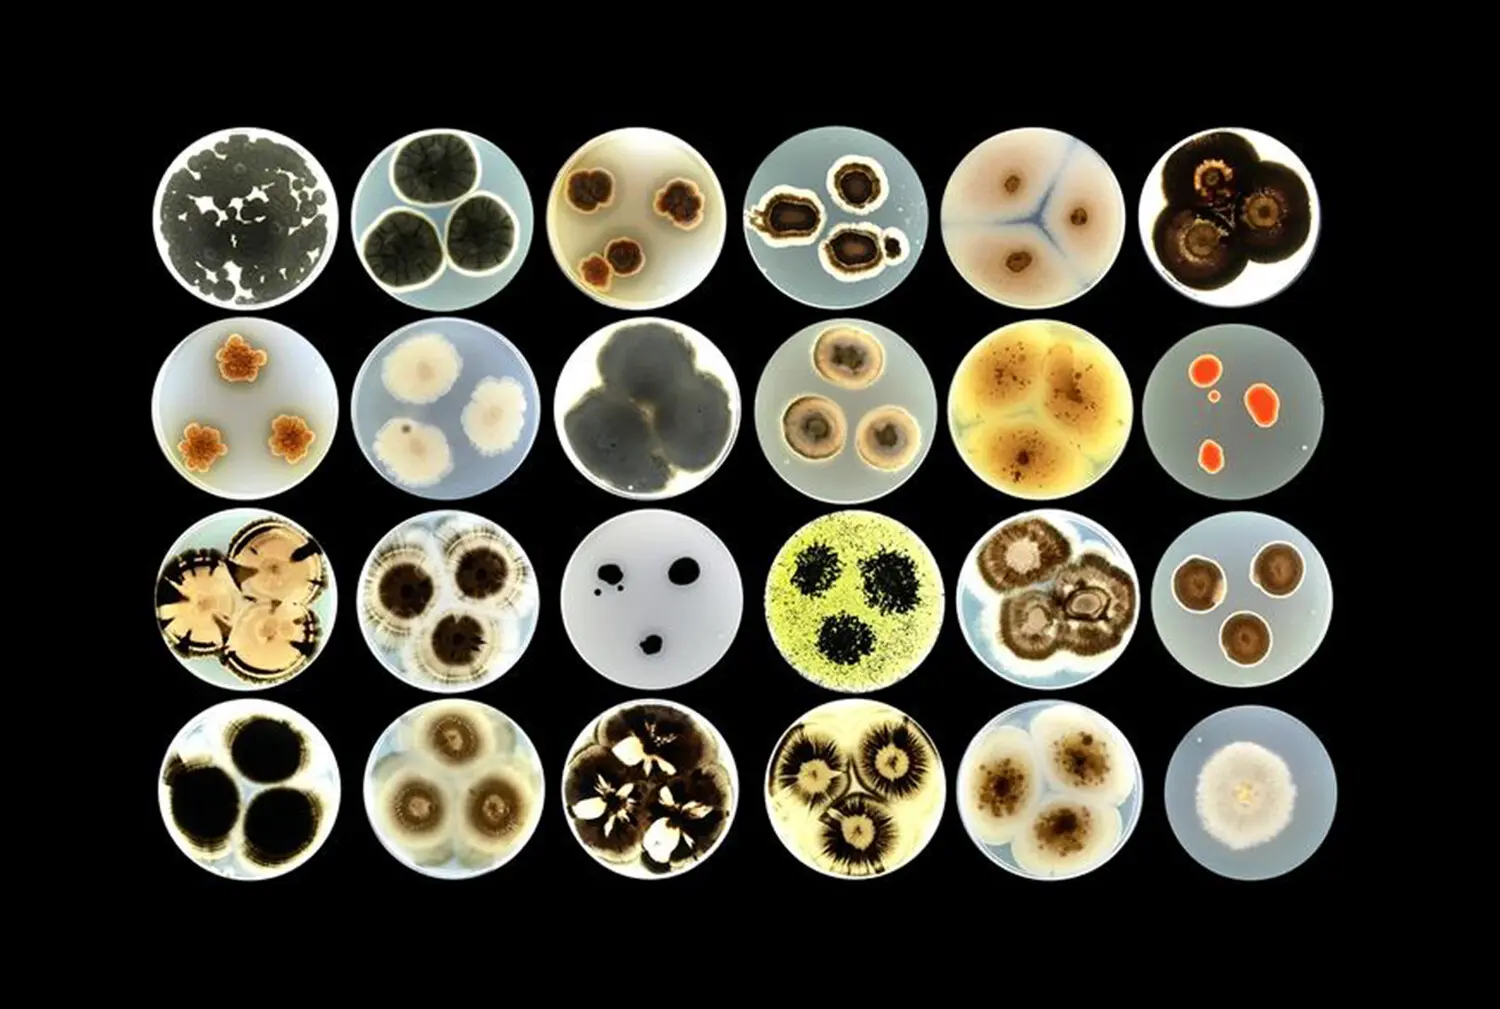

Живые татуировки для зданий: новая эра экологичных городов
Команда исследователей под руководством Нины Гунде-Цимерман из Люблянского университета открывает перед архитектурой масштабные перспективы. Проект REMEDY реализует уникальную концепцию живых татуировок для фасадов зданий. С помощью передовых биотехнологий разрабатываются биоактивные покрытия на основе специально отобранных микроорганизмов, применяемых в инновационных чернилах для струйной печати. Эти живые чернила способны не только эффективно очищать воздух и поглощать углекислый газ, но и запускать процессы самовосстановления строительных материалов — например, заживлять трещины на стенах и фасадах.
Главная задача команды — разработка живых консорциумов из бактерий, грибов и других устойчивых организмов, способных жить и функционировать на разных поверхностях: бетоне, дереве и металле. Такая комбинация позволяет покрытию надежно закрепляться и устойчиво существовать на фасадах в условиях городской среды. Это означает, что фасады будущего смогут самостоятельно противостоять времени и воздействию окружающей среды.
Инновационные компании и их вклад в экологическую трансформацию
Важным элементом внедрения живых покрытий являются партнерства с передовыми высокотехнологичными компаниями Европы. Словацкая Qres Technologies и австрийская Tiger Coatings разрабатывают специальные системы струйной печати, оптимизированные для работы с биоактивными чернилами. Для этого инженеры адаптируют традиционные печатающие головки, чтобы они могли безопасно и точно наносить на поверхность чернила, содержащие живые клетки размером всего в несколько микрометров.
Разработка подобных печатных систем выходит далеко за рамки привычных технологий и требует глубоких знаний в области биологии, материаловедения и машиностроения. Такой междисциплинарный подход обеспечивает REMEDY высочайший инновационный потенциал и делает проект флагманом в сфере экологического строительства.
Синтез биотехнологий и архитектуры: перспективы и ожидания
Как отмечает координатор инициативы Анна Сандак из InnoRenew CoE, REMEDY — это синтез науки о жизни и современной архитектуры. Создание биоактивных, интеллектуальных материалов открывает новую эпоху для городов: строения начинают жить, будто дыша вместе с мегаполисом, очищая атмосферу от вредных примесей и самостоятельно поддерживая свою структуру в отличном состоянии.
Стены и фасады, на которых нанесены живые татуировки, становятся мощными экосистемами, работающими на благо городских жителей. Такие дома не только минимизируют углеродный след, но и способствуют общему оздоровлению городской среды. Перспектива появления таких «дышащих» построек вселяет уверенность в завтрашнем дне и вдохновляет ученых по всему миру.
Оптимистичный взгляд в ближайшее будущее
По словам участницы проекта Кэрол Планшетт, внедрение эволюционирующих живых чернил в промышленной печати — настоящее научное открытие, требующее прежде всего смелости. Тем не менее, команда REMEDY с воодушевлением смотрит на будущее и верит в успех столь амбициозной задачи. Их цель — превратить стандартные городские стены в интеллектуальные биоматериалы, которые активно улучшают качество городского воздуха и способствуют экологическому балансу.
Такой подход подарит городам не просто новые технологии восстановления фасадов — он изменит само понимание архитектуры. Дома перестанут быть пассивными объектами, а превратятся в настоящих живых партнеров сообщества, заботящихся о здоровье горожан и устойчивости городской среды. Современные разработки команды Нины Гунде-Цимерман, поддерживаемые вкладом InnoRenew CoE и промышленными лидерами, обещают миру эру инновационного, чистого и более зеленого градостроительства уже в ближайшее десятилетие.
Источник: www.gazeta.ru





